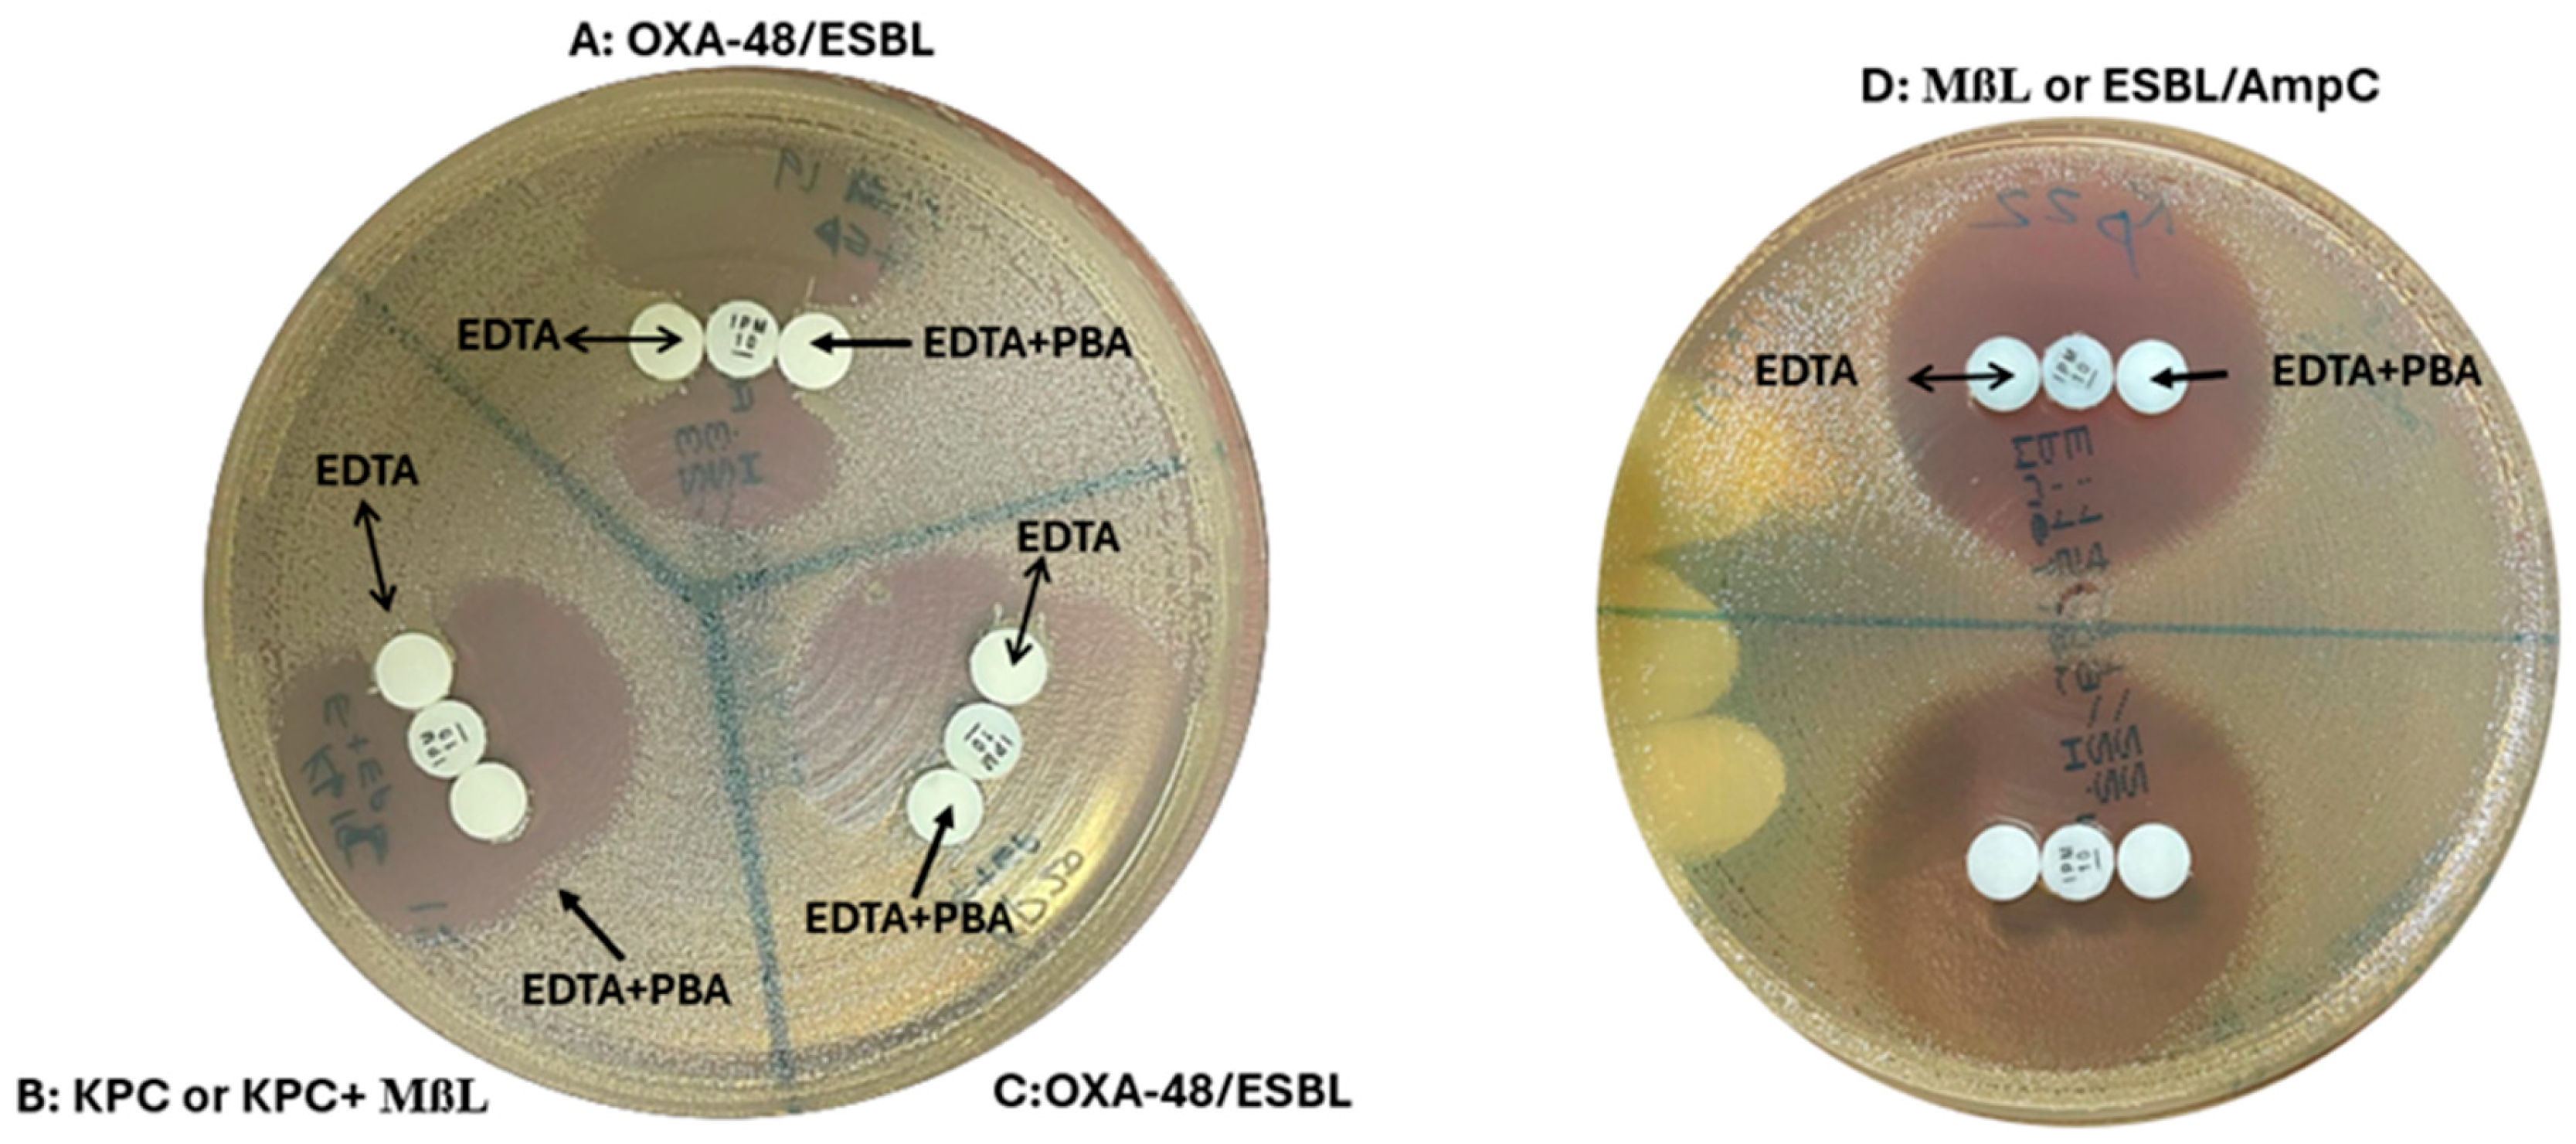
Diagnostics 15 00949 g003

Assessment of Phenotypic Tools for Detection of OXA-48, KPC, and NDM in Klebsiella pneumoniae in Oman
Abstract
1. Introduction
2. Materials and Methods
2.1. Sample Collection
2.2. Genotypic Confirmation of Carbapenemases by Gene Xpert/PCR
2.3. Whole-Genome Sequencing (WGS)
2.4. Phenotypic Testing for Screening and Confirmation of CPE
2.5. Screening Test
Temocillin and D71C Disk Test
2.6. Confirmatory Tests
2.6.1. OXA-48 Disk Test
2.6.2. MASTDISCS® Combi (D72C): AmpC, ESBL, and Carbapenemase Detection Set
2.6.3. MASTDISCS® Combi Carba Plus (D73C)
2.6.4. Immunochromatographic Assay (ICT)
2.7. Statistical Analysis
3. Results
3.1. Screening Tests
3.2. Confirmatory Tests
3.2.1. OXA-48 Disk Test
3.2.2. D72C Test
3.2.3. D73C Test
3.2.4. ICT Test
4. Discussion
5. Conclusions
Supplementary Materials
Author Contributions
Funding
Institutional Review Board Statement
Informed Consent Statement
Data Availability Statement
Conflicts of Interest
References
- Bakthavatchalam, Y.D.; Anandan, S.; Veeraraghavan, B. Laboratory Detection and Clinical Implication of Oxacillinase-48 like Carbapenemase: The Hidden Threat. J. Glob. Infect. Dis. 2016, 8, 41–50. [Google Scholar] [CrossRef] [PubMed]
- Codjoe, F.S.; Donkor, E.S. Carbapenem Resistance: A Review. Med. Sci. 2017, 6, 1. [Google Scholar] [CrossRef] [PubMed]
- Nordmann, P.; Cuzon, G.; Naas, T. The real threat of Klebsiella pneumoniae carbapenemase-producing bacteria. Lancet Infect. Dis. 2009, 9, 228–236. [Google Scholar] [CrossRef] [PubMed]
- Pitout, J.D.D.; Nordmann, P.; Poirel, L. Carbapenemase-producing Klebsiella pneumoniae, a key pathogen set for global nosocomial dominance. Antimicrob. Agents Chemother. 2015, 59, 5873–5884. [Google Scholar] [CrossRef]
- Barguigua, A.; Zerouali, K.; Katfy, K.; El Otmani, F.; Timinouni, M.; Elmdaghri, N. Occurrence of OXA-48 and DM-1 carbapenemase-producing Klebsiella pneumoniae in a Moroccan university hospital in Casablanca, Morocco. Infect. Genet. Evol. 2015, 31, 142–148. [Google Scholar] [CrossRef]
- Solgi, H.; Badmasti, F.; Giske, C.G.; Aghamohammad, S.; Shahcheraghi, F. Molecular epidemiology of NDM-1-and OXA-48-producing Klebsiella pneumoniae in an Iranian hospital: Clonal dissemination of ST11 and ST893. J. Antimicrob. Chemother. 2018, 73, 1517–1524. [Google Scholar] [CrossRef]
- Stewart, A.; Harris, P.; Henderson, A.; Paterson, D. Treatment of infections by OXA-48-producing Enterobacteriaceae. Antimicrob. Agents Chemother. 2018, 62, e01195-18. [Google Scholar] [CrossRef]
- Kanapathipillai, R.; Malou, N.; Hopman, J.; Bowman, C.; Yousef, N.; Michel, J.; Hussein, N.; Herard, P.; Ousley, J.; Mills, C.; et al. Antibiotic resistance in conflict settings: Lessons learned in the Middle East. JAC Antimicrob. Resist. 2019, 1, dlz002. [Google Scholar] [CrossRef] [PubMed] [PubMed Central]
- Greissl, C.; Saleh, A.; Hamprecht, A. Rapid detection of OXA-48-like, KPC, NDM, and VIM carbapenemases in Enterobacterales by a new multiplex immunochromatographic test. Eur. J. Clin. Microbiol. Infect. Dis. 2019, 38, 331–335. [Google Scholar] [CrossRef]
- Van Der Zee, A.; Roorda, L.; Bosman, G.; Fluit, A.C.; Hermans, M.; Smits, P.H.M.; Van Der Zanden, A.G.M.; Witt, R.; Van Es, L.; Van Coppenraet, B.; et al. Multi-centre evaluation of real-time multiplex PCR for detection of carbapenemase genes OXA-48, VIM, IMP, NDM and KPC. BMC Infect. Dis. 2014, 14, 27. [Google Scholar] [CrossRef]
- Fernández-Caso, B.; Lumbreras-Iglesias, P.; Rodicio, M.R.; Fernández, J.; Rodríguez-Lucas, C. Usefulness of inclusion of ertapenem and temocillin screening breakpoints in the EUCAST rapid antimicrobial susceptibility testing (RAST) for rapid detection of OXA-48-producing Klebsiella pneumoniae directly from positive blood cultures. J. Antimicrob. Chemother. 2024, 79, 462–466. [Google Scholar] [CrossRef] [PubMed]
- Cohen Stuart, J.; Leverstein-Van Hall, M.A. Dutch Working Party on the Detection of Highly Resistant Microorganisms. Guideline for phenotypic screening and confirmation of carbapenemases in Enterobacteriaceae. Int. J. Antimicrob. Agents 2010, 36, 205–210. [Google Scholar] [CrossRef] [PubMed]
- Van Dijk, K.; Voets, G.M.; Scharringa, J.; Voskuil, S.; Fluit, A.C.; Rottier, W.C.; Leverstein-Van Hall, M.A.; Cohen Stuart, J.W. A disc diffusion assay for detection of class A, B and OXA-48 carbapenemases in Enterobacteriaceae using phenyl boronic acid, dipicolinic acid and temocillin. Clin. Microbiol. Infect. Off. Publ. Eur. Soc. Clin. Microbiol. Infect. Dis. 2014, 20, 345–349. [Google Scholar] [CrossRef]
- Tsakris, A.; Poulou, A.; Bogaerts, P.; Dimitroulia, E.; Pournaras, S.; Glupczynski, Y. Evaluation of a new phenotypic OXA-48 disk test for differentiation of OXA-48 carbapenemase-producing Enterobacteriaceae clinical isolates. J. Clin. Microbiol. 2015, 53, 1245–1251. [Google Scholar] [CrossRef]
- Noubam-Tchatat, C.C.; Maurin, E.; Proust, S.; Beyrouthy, R.; Bonnet, R.; Robin, F. MAST® D72C test: A novel option for ESBL, AmpC and carbapenemase detection. Eur. J. Clin. Microbiol. Infect. Dis. 2024, 43, 1181–1192. [Google Scholar] [CrossRef]
- Cuffari, S.; Aiezza, N.; Antonelli, A.; Giani, T.; Rossolini, G.M. Evaluation of three commercial lateral flow immunoassays for the detection of KPC, VIM, NDM, IMP and OXA-48-like carbapenemases. J. Antimicrob. Chemother. 2024, 79, 2724–2727. [Google Scholar] [CrossRef]
- Koroska, F.; Göttig, S.; Kaase, M.; Steinmann, J.; Gatermann, S.; Sommer, J.; Wille, T.; Plum, G.; Hamprecht, A. Comparison of Phenotypic Tests and an Immunochromatographic Assay and Development of a New Algorithm for Detection of OXA-48-like Carbapenemases. J. Clin. Microbiol. 2017, 55, 877–883. [Google Scholar] [CrossRef]
- Baeza, L.L.; Pfennigwerth, N.; Greissl, C.; Göttig, S.; Saleh, A.; Stelzer, Y.; Gatermann, S.G.; Hamprecht, A. Comparison of five methods for detection of carbapenemases in Enterobacterales with proposal of a new algorithm. Clin. Microbiol. Infect. Off. Publ. Eur. Soc. Clin. Microbiol. Infect. Dis. 2019, 25, 1286.e9–1286.e15. [Google Scholar] [CrossRef]
- Doyle, D.; Peirano, G.; Lascols, C.; Lloyd, T.; Church, D.L.; Pitout, J.D. Laboratory detection of Enterobacteriaceae that produce carbapenemases. J. Clin. Microbiol. 2012, 50, 3877–3880. [Google Scholar] [CrossRef]
- Nurk, S.; Bankevich, A.; Antipov, D.; Gurevich, A.A.; Korobeynikov, A.; Lapidus, A.; Prjibelsky, A.; Pyshkin, A.; Sirotkin, A.; Sirotkin, Y.; et al. Assembling genomes and mini-metagenomes from highly chimeric reads. Nat. Biotechnol. 2013, 31, 1084–1091. [Google Scholar] [CrossRef]
- Seemann, T. Prokka: Rapid prokaryotic genome annotation. Bioinformatics 2014, 30, 2068–2069. [Google Scholar] [CrossRef] [PubMed]
- Al-Zahrani, I.A.; Aljabri, A.; Alhazmi, W.A.; Yasir, M.; Abujamel, T.; Alghamdi, A.K.; Azhar, E.I. Genomic analysis of extensively drug resistant (XDR) Klebsiella pneumoniae high-risk clone ST14 co-harboring blaNDM and blaOXA-48 recovered from Saudi Arabia. J. Infect. Public Health 2024, 17, 669–675. [Google Scholar] [CrossRef] [PubMed]
- Uelze, L.; Grützke, J.; Borowiak, M.; Hammerl, J.A.; Juraschek, K.; Deneke, C.; Tausch, S.H.; Malorny, B. Typing methods based on whole genome sequencing data. One Health Outlook 2020, 2, 3. [Google Scholar] [CrossRef] [PubMed]
- Larsen, M.V.; Cosentino, S.; Rasmussen, S.; Friis, C.; Hasman, H.; Marvig, R.L.; Jelsbak, L.; Sicheritz-Pontéen, T.; Ussery, D.W.; Aarestrup, F.M.; et al. Multilocus sequence typing of total-genome-sequenced bacteria. J. Clin. Microbiol. 2012, 50, 1355–1361. [Google Scholar] [CrossRef]
- Carattoli, A.; Zankari, E.; García-Fernández, A.; Voldby Larsen, M.; Lund, O.; Villa, L.; Møller Aarestrup, F.; Hasman, H. In silico detection and typing of plasmids using PlasmidFinder and plasmid multilocus sequence typing. Antimicrob. Agents Chemother. 2014, 58, 3895–3903. [Google Scholar] [CrossRef]
- Bortolaia, V.; Kaas, R.S.; Ruppe, E.; Roberts, M.C.; Schwarz, S.; Cattoir, V.; Philippon, A.; Allesoe, R.L.; Rebelo, A.R.; Florensa, A.F.; et al. ResFinder 4.0 for predictions of phenotypes from genotypes. J. Antimicrob. Chemother. 2020, 75, 3491–3500. [Google Scholar] [CrossRef]
- Giske, C.G.; Martinez-Martinez, L.; Canton, R.; Stefani, S.; Skov, R.; Glupczynski, Y.; Nordmann, P.; Wootton, M.; Miriagou, V.; Skov Simonsen, G.; et al. EUCAST Guidelines for Detection of Resistance Mechanisms and Specific Resistances of Clinical and/or Epidemiological Importance, Version 1.0. 2013. Available online: http://www.eucast.org/fileadmin/src/media/PDFs/EUCAST_files/Resistance_mechanisms/EUCAST_detection_of_resistance_mechanisms_v1.0_20131211.pdf (accessed on 16 September 2022).
- Huang, T.D.; Poirel, L.; Bogaerts, P.; Berhin, C.; Nordmann, P.; Glupczynski, Y. Temocillin and piperacillin/tazobactam resistance by disc diffusion as antimicrobial surrogate markers for the detection of carbapenemase-producing Enterobacteriaceae in geographical areas with a high prevalence of OXA-48 producers. J. Antimicrob. Chemother. 2014, 69, 445–450. [Google Scholar] [CrossRef]
- Shaker, O.A.; Gomaa, H.E.; ElMasry, S.A.; Abdel Halim, R.M.; Abdelrahman, A.H.; Kamal, J.S. Evaluation of Combined Use of Temocillin Disk and Mastdisks Inhibitor Combination Set Against Polymerase Chain Reaction for Detection of Carbapenem-Resistant Enterobacteriaceae. Open Access Maced. J. Med. Sci. 2018, 6, 242–247. [Google Scholar] [CrossRef]
- Franklin, C.; Liolios, L.; Peleg, A.Y. Phenotypic detection of carbapenem-susceptible metallo-β-lactamase-producing gram-negative bacilli in the clinical laboratory. J. Clin. Microbiol. 2006, 44, 3139–3144. [Google Scholar] [CrossRef]
- Tsakris, A.; Kristo, I.; Poulou, A.; Themeli-Digalaki, K.; Ikonomidis, A.; Petropoulou, D.; Pournaras, S.; Sofianou, D. Evaluation of boronic acid disk tests for differentiating KPC-possessing Klebsiella pneumoniae isolates in the clinical laboratory. J. Clin. Microbiol. 2009, 47, 362–367. [Google Scholar] [CrossRef]
- Al Mamari, A.M.K.; Al Jabri, Z.; Sami, H.; Rizvi, S.G.A.; Chan, M.F.; Al Siyabi, T.; Al Muharrmi, Z.; Rizvi, M. Evaluation of six commercial and in-house phenotypic tests for detection of AmpC β-lactamases: Is routine detection possible? JAC Antimicrob. Resist. 2023, 5, dlad101. [Google Scholar] [CrossRef] [PubMed]
- Han, R.; Guo, Y.; Peng, M.; Shi, Q.; Wu, S.; Yang, Y.; Zheng, Y.; Yin, D.; Hu, F. Evaluation of the Immunochromatographic NG-Test Carba 5, RESIST-5 O.O.K.N.V., and IMP K-SeT for Rapid Detection of KPC-, NDM-, IMP-, VIM-type, and OXA-48-like Carbapenemase Among Enterobacterales. Front. Microbiol. 2021, 11, 609856. [Google Scholar] [CrossRef] [PubMed]
- Saleh, A.; Göttig, S.; Hamprecht, A.G. Multiplex Immunochromatographic Detection of OXA-48, KPC, and NDM Carbapenemases: Impact of Inoculum, Antibiotics, and Agar. J. Clin. Microbiol. 2018, 56, e00050-18. [Google Scholar] [CrossRef] [PubMed]
- Bogaerts, P.; Berger, A.S.; Evrard, S.; Huang, T.D. Comparison of two multiplex immunochromatographic assays for the rapid detection of major carbapenemases in Enterobacterales. J. Antimicrob. Chemother. 2020, 75, 1491–1494. [Google Scholar] [CrossRef]
- Safari, S.; Baratloo, A.; Elfil, M.; Negida, A. Evidence Based Emergency Medicine Part 2: Positive and negative predictive values of diagnostic tests. Emergency 2015, 3, 87–88. [Google Scholar]
- Balkhair, A.; Al-Farsi, Y.M.; Al-Muharrmi, Z.; Al-Rashdi, R.; Al-Jabri, M.; Neilson, F.; Al-Adawi, S.; El-Beeli, M.; Al-Adawi, S. Epidemiology of multi-drug resistant organisms in a teaching hospital in Oman: A one-year hospital-based study. Sci. World J. 2014, 2014, 157102. [Google Scholar] [CrossRef]
- Loon, K.; Holt, A.; Vos, M. A Systematic Review and Meta-Analyses of the Clinical Epidemiology of Carbapenem-Resistant Enterobacteriaceae. Antimicrob. Agents Chemother. 2017, 62, e01730-17. [Google Scholar] [CrossRef]
- Sonnevend, A.; Ghazawi, A.A.; Hashmey, R.; Jamal, W.; Rotimi, V.O.; Shibl, A.M.; Al-Jardani, A.; Al-Abri, S.S.; Tariq, W.U.Z.; Weber, S.; et al. Characterization of carbapenem-resistant Enterobacteriaceae with high rate of autochthonous transmission in the Arabian Peninsula. PLoS ONE 2015, 10, e0131372. [Google Scholar] [CrossRef]
- Zarakolu, P.; Day, K.M.; Sidjabat, H.E.; Kamolvit, W.; Lanyon, C.V.; Cummings, S.P.; Paterson, D.L.; Akova, M. Evaluation of a new chromogenic medium, chromID OXA-48, for recovery of carbapenemase-producing Enterobacteriaceae from patients at a university hospital in Turkey. Eur. J. Clin. Microbiol. Infect. Dis. 2014, 34, 519–525. [Google Scholar] [CrossRef]
- Boyd, S.E.; Holmes, A.; Peck, R.; Livermore, D.M.; Hope, W. OXA-48-Like β-Lactamases: Global Epidemiology, Treatment Options, and Development Pipeline. Antimicrob. Agents Chemother. 2022, 66, e00216-22. [Google Scholar] [CrossRef]
- Poirel, L.; Al Maskari, Z.; Al Rashdi, F.; Bernabeu, S.; Nordmann, P. NDM-1-producing Klebsiella pneumoniae isolated in the Sultanate of Oman. J. Antimicrob. Chemother. 2011, 66, 304–306. [Google Scholar] [CrossRef] [PubMed]
- Dortet, L.; Poirel, L.; Al Yaqoubi, F.; Nordmann, P. NDM-1, OXA-48 and OXA-181 carbapenemase-producing Enterobacteriaceae in Sultanate of Oman. Clin. Microbiol. Infect. 2012, 18, E144–E148. [Google Scholar] [CrossRef] [PubMed]
- Al-Farsi, H.M.; Camporeale, A.; Ininbergs, K.; Al-Azri, S.; Al-Muharrmi, Z.; Al-Jardani, A.; Giske, C.G. Clinical and molecular characteristics of carbapenem non-susceptible Escherichia coli: A nationwide survey from Oman. PLoS ONE 2020, 15, e0239924. [Google Scholar] [CrossRef]
- AL-Quraini, M.; Rizvi, M.; AL-Jabri, Z.; Sami, H.; AL-Muzahmi, M.; AL-Muharrmi, Z.; Taneja, N.; AL-Busaidi, I.; Soman, R. Assessment of In-Vitro Synergy of Fosfomycin with Meropenem, Amikacin and Tigecycline in Whole Genome Sequenced Extended and Pan Drug Resistant Klebsiella pneumoniae: Exploring A Colistin Sparing Protocol. Antibiotics 2022, 11, 153. [Google Scholar] [CrossRef]
- Al-Muzahmi, M.; Rizvi, M.; Al-Quraini, M.; Al-Muharrmi, Z.; Al-Jabri, Z. Comparative Genomic Analysis Reveals the Emergence of ST-231 and ST-395 Klebsiella pneumoniae Strains Associated with the High Transmissibility of blaKPC Plasmids. Microorganisms 2023, 11, 2411. [Google Scholar] [CrossRef]
- Al-Balushi, M.A.; Kumar, R.; Al-Rashdi, A.; Ratna, A.; Al-Jabri, A.; Al-Shekaili, N.; Rani, R.; Sumri, S.A.; Al-Ghabshi, L.; Al-Abri, S.; et al. Genomic analysis of the emerging carbapenem-resistant Klebsiella pneumoniae sequence type 11 harbouring Klebsiella pneumoniae carbapenemase (KPC) in Oman. J. Infect Public Health 2022, 15, 1089–1096. [Google Scholar] [CrossRef] [PubMed]
- Hartl, R.; Widhalm, S.; Kerschner, H.; Apfalter, P. Temocillin and meropenem to discriminate resistance mechanisms leading to decreased carbapenem susceptibility with focus on OXA-48 in Enterobacteriaceae. Clin. Microbiol. Infect. 2013, 19, E230–E232. [Google Scholar]
- Al-Zahrani, I.A.; Alasiri, B.A. The emergence of carbapenem-resistant Klebsiella pneumoniae isolates producing OXA-48 and NDM in the Southern (Asir) province, Saudi Arabia. Saudi Med. J. 2018, 39, 23. [Google Scholar]
- Glupczynski, Y.; Evrard, S.; Ote, I.; Mertens, P.; Huang, T.D.; Leclipteux, T.; Bogaerts, P. Evaluation of two new commercial immunochromatographic assays for the rapid detection of OXA-48 and KPC carbapenemases from cultured bacteria. J. Antimicrob. Chemother. 2016, 71, 1217–1222. [Google Scholar]
- Josa, M.D.; Leal, R.; Rojas, J.; Torres, M.I.; Cortés-Muñoz, F.; Esparza, G.; Reyes, L.F. Comparative Evaluation of Phenotypic Synergy Tests Versus RESIST-4 O.K.N.V. and NG Test Carba 5 Lateral Flow Immunoassays for the Detection and Differentiation of Carbapenemases in Enterobacterales and Pseudomonas aeruginosa. Microbiol. Spectr. 2022, 10, e0108021. [Google Scholar] [CrossRef] [PubMed] [PubMed Central]

| Carbapenemase | Gold Standard | Screening Test | Confirmatory Tests | ||||
|---|---|---|---|---|---|---|---|
| In-House | Commercial Tests | ||||||
| Xpert Carba-R/PCR | Temocillin Disc Test | D71C | OXA-48 Disk Test | D72C | D73C (n = 32) | ICT | |
| N (%) | N (%) | N (%) | N (%) | N (%) | N (%) | N (%) | |
| OXA-48 (n = 40) | 40 (100%) | 40 (100%) | 39 (97.5%) | 38 (95%) | 39 (97.5%) | 19 (95%) * | 40 (97.5%) |
| KPCs (n = 20) | 20 (100%) | 18 (90%) | 20 (100%) | 20 (100%) | 20 (100%) | 5 (83.3%) ** | 19 (95%) |
| NDM (n = 20) | 20 (100%) | 18 (90%) | 20 (100%) | 20 (100%) | 20 (100%) | 6 (100%) *** | 19 (95%) |
| Carbapenemase | Gold Standard | Screening Test | Confirmatory Tests | Extended Spectrum β-Lactam Genes | |||||
|---|---|---|---|---|---|---|---|---|---|
| In-House | Commercial Tests | ||||||||
| WGS | Temocillin Disk Test | D71C | OXA-48 Disk Test | D72C | D73C (n = 32) | ICT | Xpert Carba-R/PCR | ||
| N (%) | N (%) | N (%) | N (%) | N (%) | N (%) | N (%) | N (%) | ||
| OXA-232 (n = 25) | 25 (100%) | 25 (100%) | 25 (100%) | 22 (88%) | 25 (100%) | 19 (95%) * | 20 (100%) | 25 (100%) | CTX-M-15, SHV-11, SHV-28, SHV-67, SHV-75. SHV106, SHV-182 |
| KPC-2+NDM-1 (n = 6) | 6 (100%) | 2 (33.3%) | 6 (100%) | 5 (83.3%) | 6 (100%) | 5 (83.3%) ** | 5 (83.3%) | 6 (100%) | CTMX-65, SHV-12, SHV-12 and SHV-182 and SHV-182 |
| NDM-5 (n = 6) | 6 (100%) | 1 (20%) | 6 (100%) | 6 (100%) | 6 (100%) | 6 (100%) *** | 6 (100%) | 6 (100%) | CTX-M-65, TEM-1B, TEM1C, SHV-11, SHV-12, SHV-67, SHV-75 |
| Gold Standards | Screening Test (%) | Confirmatory Tests (%) | |||||
|---|---|---|---|---|---|---|---|
| In-House Test | Commercial Tests | ||||||
| Temocillin | D71C | OXA-48 Disk | D72C | D73C | ICT | ||
| WGS (n = 37) | SN (%) | 100 | 100 | 100 | 100 | 96.15 | 100 |
| SP (%) | 76.92 | 100 | 91.67 | 100 | 91.67 | 92.31 | |
| PPV (%) | 89.29 | 100 | 95.65 | 100 | 96.15 | 96.15 | |
| NPV (%) | 100 | 100 | 100 | 100 | 91.67 | 100 | |
| X-pert Carba-R/PCR (n = 80) | SN (%) | 100 | 97.5 | 92.5 | 97.5 | 95 | 100 |
| SP (%) | 70 | 100 | 100 | 100 | 91.67 | 95 | |
| PPV (%) | 76.92 | 100 | 100 | 100 | 95 | 95.24 | |
| NPV (%) | 100 | 97.56 | 93.02 | 97.56 | 91.67 | 100 | |
Disclaimer/Publisher’s Note: The statements, opinions and data contained in all publications are solely those of the individual author(s) and contributor(s) and not of MDPI and/or the editor(s). MDPI and/or the editor(s) disclaim responsibility for any injury to people or property resulting from any ideas, methods, instructions or products referred to in the content. |
© 2025 by the authors. Licensee MDPI, Basel, Switzerland. This article is an open access article distributed under the terms and conditions of the Creative Commons Attribution (CC BY) license (https://creativecommons.org/licenses/by/4.0/).
Share and Cite
Rujaibi, A.A.; Jabri, Z.A.; Jardani, A.A.; Rashdi, A.A.; Mamari, A.A.; Sumri, S.A.; Sami, H.; Muharrmi, Z.A.; Rizvi, M. Assessment of Phenotypic Tools for Detection of OXA-48, KPC, and NDM in Klebsiella pneumoniae in Oman. Diagnostics 2025, 15, 949. https://doi.org/10.3390/diagnostics15080949
Rujaibi AA, Jabri ZA, Jardani AA, Rashdi AA, Mamari AA, Sumri SA, Sami H, Muharrmi ZA, Rizvi M. Assessment of Phenotypic Tools for Detection of OXA-48, KPC, and NDM in Klebsiella pneumoniae in Oman. Diagnostics. 2025; 15(8):949. https://doi.org/10.3390/diagnostics15080949
Chicago/Turabian StyleRujaibi, Arwa AL, Zaaima AL Jabri, Amina Al Jardani, Azza AL Rashdi, Azza AL Mamari, Sara AL Sumri, Hiba Sami, Zakariya Al Muharrmi, and Meher Rizvi. 2025. "Assessment of Phenotypic Tools for Detection of OXA-48, KPC, and NDM in Klebsiella pneumoniae in Oman" Diagnostics 15, no. 8: 949. https://doi.org/10.3390/diagnostics15080949
APA StyleRujaibi, A. A., Jabri, Z. A., Jardani, A. A., Rashdi, A. A., Mamari, A. A., Sumri, S. A., Sami, H., Muharrmi, Z. A., & Rizvi, M. (2025). Assessment of Phenotypic Tools for Detection of OXA-48, KPC, and NDM in Klebsiella pneumoniae in Oman. Diagnostics, 15(8), 949. https://doi.org/10.3390/diagnostics15080949

